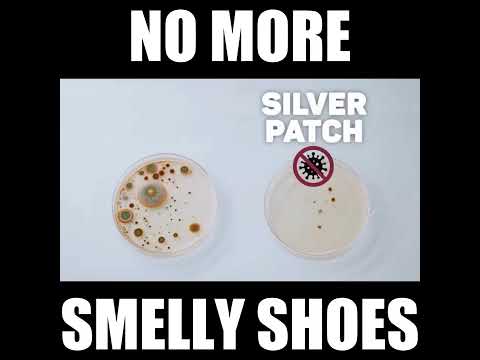
Video

What does it mean to back a project (pledge)?
When you back a project, you are pre-ordering the product. That means you will get it once it's produced. Besides getting the product itself, you're also joining a community. Follow along the production process, take part in important surveys and give the creator valuable feedback.
What is Kickstarter?
Kickstarter is a launchpad for creators to raise funds for the initial production of their invention. Backers (that's you!) can support the creator by pre-ordering the product at a discounted price.
How do I pledge?
In order to pledge, click that green button that says Back this project . You will get to select your shipping country and choose your desired pledge level and reward.
No waiting, no pledging — just a proven Kickstarter hit you can get right now.
🎁 Extra 10% off with code RP10
View on First Backer Shop →